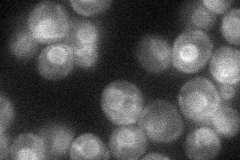
YCR021C
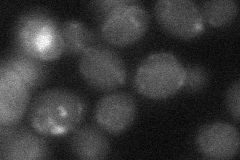
YCR021C
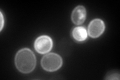
YCR021C

View description
Hydrophobic plasma membrane localized, stress-responsive protein that negatively regulates the H(+)-ATPase Pma1p; induced by heat shock, ethanol treatment, weak organic acid, glucose limitation, and entry into stationary phase
Localization:
Intensity:
Fold change:
Significance:
-
C’ GFP library in SD

cell periphery154.36 -
N' NOP1pr-GFP in SD
ER38.9516 -
N' TEF2pr-mCherry in SD

punctate16.7298 -
N' NATIVEpr-GFP in SD

below threshold25.4305 -
N' TEF2pr-VC and Cyto-VN in SD
below threshold24.3181 -
C’ GFP library in SD+DTT

cell peripheryN/AN/ANo -
C’ GFP library in SD+H2O2

cell peripheryN/AN/ANo -
C’ GFP library in Starvation Media
cell peripheryN/AN/AYes -
C’ GFP library on the background of Pup2-DaMP

cell periphery -
C’ GFP library on the background of CCT mutant

cell peripheryN/AN/ANo
